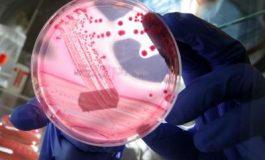
featured 2100210 265x160

Covid, due vaccini meglio di uno: Usa consigliano doppia dose per evitare ricoveri
Negli Stati Uniti viene consigliata una doppia dose di vaccino anti-Covid aggiornato agli anziani e ai fragili tra il 2024 e il 2025. La direttrice dei Centers for Disease Control and Prevention, Mandy Cohen, ha approvato la raccomandazione del comitato consultivo Acip per le vaccinazioni (Advisory ...